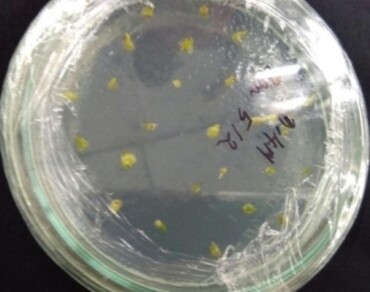
Cryopreservation of shoot meristems of Baliospermum montanum (Willd.) Muell. Arg. for long-term conservation and sustainable utilization

Vol 37 Issue 6, December 2024
Total Articles: 47

Exogenous applications of caffeic acid affect the essential oils of marigold cultivars planted on sandy soil
Research Articles
Views: 3117
Pages: 2283-2293
Published: 14 September, 2023
Doi: 10.1007/s42535-023-00718-x

Quantification of β -ODAP content in seeds of Lathyrus aphaca L: a minor crop species of local importance
Research Articles
Views: 3948
Pages: 2294-2300
Published: 14 September, 2023
Doi: 10.1007/s42535-023-00734-x

Genetics of yield contributing traits with emphasis on seed traits in segregating generations of chickpea (Cicer arietinum L.)
Research Articles
Views: 3558
Pages: 2301-2310
Published: 14 September, 2023
Doi: 10.1007/s42535-023-00729-8

Cadmium biosorption and plant growth promotion efficacy of a metalloresistant Pseudomonas sp. unveils augmented growth with reduced metal accumulation in Brassica napus L.
Research Articles
Views: 3771
Pages: 2311-2319
Published: 15 September, 2023
Doi: 10.1007/s42535-023-00724-z

Evaluation of physicochemical, phytochemical, anti-bacterial and antioxidant potential of kola nut (cola acuminata): an approach in food, health and nutritional benefits
Research Articles
Views: 4367
Pages: 2320-2329
Published: 15 September, 2023
Doi: 10.1007/s42535-023-00715-0

Clustering based on morphological marker through linear discriminant analysis targeting potent yield enhancers in mini-core collections of chickpea (Cicer arietinum L.)
Research Articles
Views: 3655
Pages: 2330-2338
Published: 18 September, 2023
Doi: 10.1007/s42535-023-00716-z

A mathematical model to elucidate of photosynthetic apparatus in noni (Morinda citrifolia L.) to temperature stress
Research Articles
Views: 3258
Pages: 2339-2346
Published: 21 September, 2023
Doi: 10.1007/s42535-023-00725-y

Evaluation of nutraceutical property of extruded breakfast cereal produced from blends of malted finger millet (Eleusine coracana) and watermelon (Citrullus lanatus) seed flour
Research Articles
Views: 3872
Pages: 2347-2361
Published: 23 September, 2023
Doi: 10.1007/s42535-023-00728-9
Cryopreservation of shoot meristems of Baliospermum montanum (Willd.) Muell. Arg. for long-term conservation and sustainable utilization
Research Articles
Views: 3639
Pages: 2362-2371
Published: 25 September, 2023
Doi: 10.1007/s42535-023-00720-3